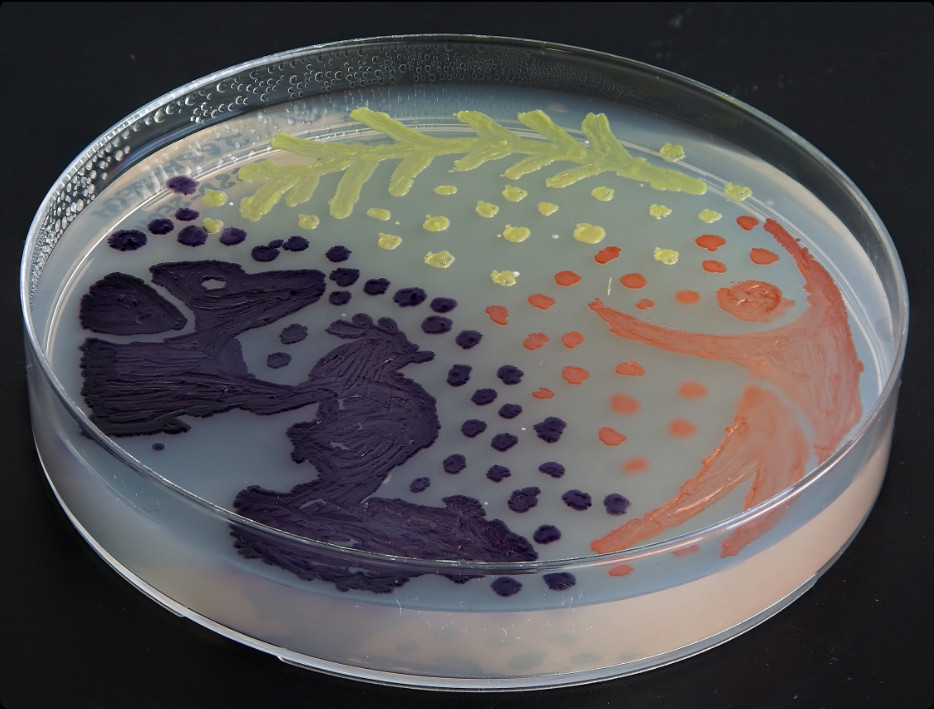
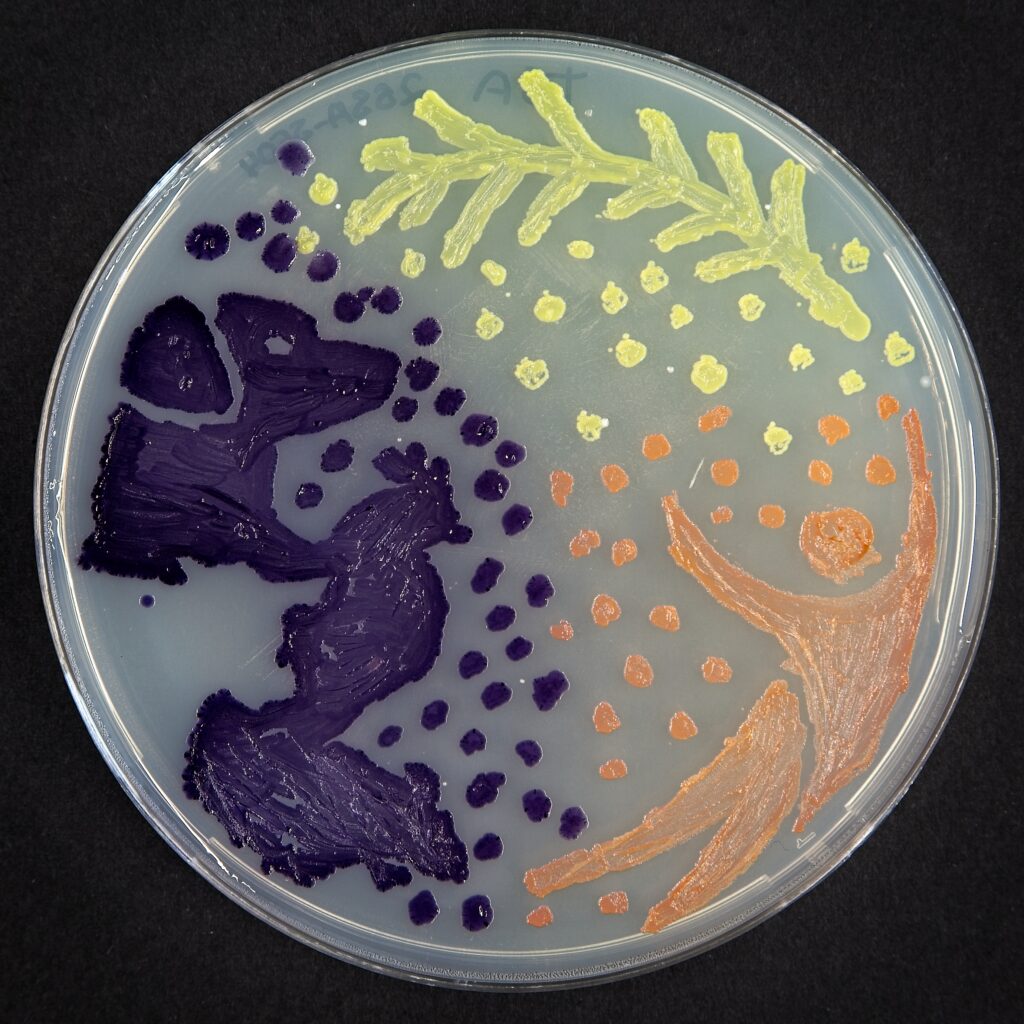

El IES Senara obtiene por segundo año consecutivo el primer premio en el concurso de arte con microorganismos del proyecto Micromundo
El 24 de abril, los diecisiete alumnos del IES Senara matriculados en la asignatura Laboratorio de Ciencias de 4.º ESO, que participaron en el proyecto de investigación “En busca de microorganismos productores de nuevos antibióticos en suelos” integrado en el proyecto internacional Small WorId Initiative-Micromundo, asistieron al acto de clausura de este proyecto.
El acto tuvo lugar en el salón de actos del edificio Dioscórides de la Facultad de Biología de la Universidad de Salamanca. Dicho acto contó con la intervención de D. Raúl Rivas González, director de la Unidad de Cultura Científica y de la Innovación de la Universidad de Salamanca. Dª. Olga Calvo García, directora del Instituto de Biología Funcional y Genómica (USAL/CSIC), D. José Ángel Sánchez Agudo, decano de la Facultad de Biología y Dª. Beatriz Santos Romero, profesora de la Facultad de Biología y coordinadora del proyecto Micromundo.
A continuación, Dª Elisa Pérez Ramírez, veterinaria y viróloga, del Deparmento de Enfermedades Infecciosas del Centro de Investigación en Sanidad Animal, del Consejo Superior de Investigaciones Científicas (CSIC), impartió una amena charla “Salud Global: la profunda conexión entre salud humana, animal y medioambiental”.
Una vez concluida la charla impartida por Dª Elisa Pérez Ramírez, se presentaron los datos obtenidos en el proyecto Micromundo 2025 y se hizo entrega de un diploma a todos los participantes en el proyecto, que este año contó con la participación de alumnos del IES Senara, IES Fernando de Rojas, IES Martínez Uribarri y Colegio San Juan Bosco, así como familias pertenecientes a la asociación Atenea, de altas capacidades intelectuales.
Para finalizar el acto, se hizo entrega de los premios del concurso de arte con microorganismos, resultando ganadoras las alumnas Celia González Sánchez y Mara García Domínguez del IES Senara. Dicho concurso consistía en dibujar en placas de Petri, utilizando bacterias de diferentes colores, imágenes relacionadas con One Health o Una Salud. One Health (Una Salud) es un concepto sanitario sobre el que se tenía constancia desde hace tiempo, que define y propone un abordaje conjunto y global entre tres ámbitos interrelacionados: la salud humana, la salud animal y el medio ambiente. El objetivo es que la salud pública, la medicina, la sanidad, la veterinaria y las ciencias ambientales, junto con otras disciplinas, trabajen de manera conjunta para defender una única salud o salud global. En la charla impartida por Dª. Elisa Pérez Ramírez quedó muy claro la profunda conexión entre estos tres ámbitos de la salud.

Comentarios recientes